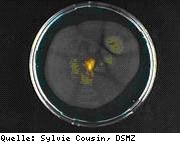

| • | Erläuterungen zu den Umwelttechnischen Berufen |
| http://www.ut-berufe.org/ | |
| • | Berufsinformationen Fachkraft für Abwasser – Informationen von der Bundesagentur für Arbeit (Berufenet) |
| http://infobub.arbeitsagentur.de/berufe/start?dest=profession&prof-id=14755 | |
| • | Ausbildungsvertrag UT Berufe – Muster der Bayerischen Verwaltungsschule |
| www.bvs.de/download/1/ausbildungsvertrag_ut_2006.doc | |
| • | Ausbildungsplan Fachkraft für Abwassertechnik – Formular für tabellarische Übersicht des betrieblichen Ausbildungsplans |
| www.bvs.de/download/1/ausbildungsplan_formular_fachkraftfuerabwassertechnik_aktuell.dot | |
| • | Ausbildungsverordnung mit Ausbildungsrahmenplan – Fachkraft für Abwasser |
| www.bvs.de/download/1/vo_ut_berufe_abwasser.pdf | |
| • | Berichtsheft – Muster für Berichtsheft |
| www.bvs.de/download/1/ausbildungsnachweis_berichtsheft_ut.doc | |
| • | Gliederung und Bewertung der Abschlussprüfung – Gewichtung und Dauer der einzelnen Prüfungsbereiche |
| www.bvs.de/download/1/bewertung_pruefungsergebnisse_fk_ut.pdf | |
| • | Rahmenlehrplan mit Lernfeldern – Übersicht über die Lernfelder mit Zielformulierung sowie Inhalte |
| http://www.ls-bw.de/beruf/lp/BS_Lernfelder/BS_Fachkraft-fuer-Abwassertechnik_03_3329.pdf | |
| • | Änderungstarifvertrag Nr. 2 zum TVAöD – Besonderer Teil BBiG |
| www.vka.de/media/exe/12/5701052c5601c77ee26a2b16d9c8d3c0/080723_2._aenderungstv_zum_tvaoed_-_bt_bbig.pdf | |
| • | Tarifvertrag für Auszubildende des öffentlichen Dienstes (TVAöD) Allgemeiner Teil |
| http://www.bib-info.de/fileadmin/media/Dokumente/Kommissionen/Kommission_Eingruppierung_und_Besoldung/Tarif_und_Besoldungsrecht/Azubis_Bund_Gemeinden/TVAauszubildende-AT.pdf | |
| • | Tarifvertrag für Auszubildende des öffentlichen Dienstes (TVAöD) – Sonderzahlungen, Einmalzahlungen |
| http://www.bib-info.de/fileadmin/media/Dokumente/Kommissionen/Kommission_Eingruppierung_und_Besoldung/Tarif_und_Besoldungsrecht/Azubis_Bund_Gemeinden/TVAoeD-AT-Anlage1-5.pdf | |
| • | Berufsbildungsgesetz(BBiG) |
| www.bmbf.de/pub/bbig_20050323.pdf | |
| • | Gesetz zum Schutz der arbeitenden Jugend(Jugendarbeitsschutzgesetz -JArbSchG) |
| www.bundesrecht.juris.de/bundesrecht/jarbschg/gesamt.pdf |
Informationen für Auszubildende
Sammlung von Prüfungsaufgaben
Nutzen Sie die hier bereitgestellten Prüfungsaufgaben der Bayerischen Verwaltungsschule und der Bezirksregierung Düsseldorf zum Üben und zur Überprüfung Ihres Kenntnisstandes. Diskutieren Sie Ihre Lösungen mit anderen Auszubildenden oder Ihrem Ausbilder.
Zwischenprüfungen Fachkräfte UT Berufe
Abschlussprüfungen Fachkräfte UT Berufe
Abschlussprüfungen Elektro (Elektrofachkraft)
Klimawandel kann zur Verbreitung von Krankheitsüberträgern führen
 Europäische Fachleute raten zur verstärkten Beobachtung, um frühzeitig Gefahren zu erkennen und handeln zu können
Europäische Fachleute raten zur verstärkten Beobachtung, um frühzeitig Gefahren zu erkennen und handeln zu können
Martin Ittershagen, Pressestelle
Umweltbundesamt (UBA)
17.10.2007
Das Klima ist wesentlich für das Überleben und die Verbreitung von Krankheitserregern mit verantwortlich – auch für die Anzahl der im Freiland lebenden Überträger (Vektoren), beispielsweise Mücken, Zecken oder Nagetiere. So lautet das zentrale Ergebnis einer internationalen Tagung mit rund 140 Fachleuten, die das Umweltbundesamt (UBA) mit finanzieller Förderung des Bundesministeriums für Gesundheit (BMG) in Berlin organisierte. Für die menschliche Gesundheit haben von Tieren übertragene Krankheiten eine besondere Bedeutung, weil im Freiland lebende Überträger unmittelbar auf klimatische Veränderungen reagieren. Mit dem Klimawandel steigt das Risiko, dass neue und teilweise gefährlichere Krankheiten in Deutschland heimisch werden könnten. Im Freiland lebende Überträger werden zudem über globale Transportwege in entfernte Regionen verschleppt. Treffen beispielsweise Mücken, Zecken oder Nagetiere am Ankunftsort auf für sie passende klimatische Bedingungen, Biotope und Wirte, so können sich die Überträger vermehren und verbreiten. Daher ist es nach Meinung der Expertinnen und Experten wichtig, auch in Deutschland systematisch im Freiland lebende Überträger zu überwachen (Vektorüberwachung). Nur so lassen sich mögliche Gefahren frühzeitig erkennen und Gegenmaßnahmen entwickeln.
Es gibt Anzeichen, dass einheimische Mücken- und Zeckenarten bereits auf die sich ändernden klimatischen Bedingungen reagieren. So verkürzen Zecken, die unter anderem Borreliose sowie Hirnhaut- und Gehirnentzündungen übertragen, regional ihre Winterruhephase. Infolge des letzten, milden Winters gab es dieses Jahr in Deutschland mehr Zecken. Mücken konnten zeitiger im Frühjahr erscheinen oder schneller ihre Entwicklung abschließen. Regional kam es diesen Sommer häufiger zu Mückenplagen. Eine in Deutschland neuerdings vereinzelt nachgewiesene Schmetterlingsmückenart überträgt die ursprünglich im Mittelmeerraum heimische Leishmaniose. In Deutschland erworbene Leishmanioseerkrankungen bei einem Kind und bei einigen Hunden zeigen, was geschehen kann, wenn bisher hier nicht heimische Vektoren und Krankheitserreger klimatisch passende Bedingungen vorfinden.
Auch für die Ausbreitung der Blauzungenkrankheit bei Wiederkäuern, hat der beobachtete Klimawandel eine wichtige Bedeutung bei der Ausbreitung von Nordafrika nach Süd- und Südwesteuropa. Die Temperaturabhängigkeit der Erreger sowie Verschleppungen, die mit Tiertransporten entstehen, gelten als wesentliche Ursachen dafür, dass sich die Erreger seit dem letzten Jahr in Belgien, den Niederlanden, in Deutschland und in England verbreiteten.
Um mögliche Gefahren frühzeitig zu erkennen und Gegenmaßnahmen entwickeln zu können, halten es Klima- und Insektenforscher, Zoologen sowie Mediziner aus 14 europäischen Ländern für notwendig, die Vektorvorkommen systematisch zu überwachen. Die nationalen Überwachungsprogramme für übertragbare Krankheiten befassen sich bisher überwiegend mit den Erkrankungen des Menschen. Überwachungsprogramme für Überträger – wie Mücken oder Zecken – gibt es nur in einzelnen europäischen Ländern. In Deutschland fehlen sie. Sie sind aber nach Meinung der Fachleute erforderlich, um Gegenmaßnahmen frühzeitig mit Infektionsschutz und dem Umweltschutz in Einklang zu konzipieren und bei Bedarf anwenden zu können.
Ausführlichere Informationen zur Tagung „Vector-borne diseases: Impact of climate change on vectors and rodent reservoirs“ finden Sie im Internet unter: http://www.adelphi-consult.com/climate-and-vectors. Die Zusammenfassungen der Tagungsergebnisse stehen in Kürze auf der UBA-Homepage.
Informationen zum Kompetenzzentrum Klimafolgen und Anpassung am Umweltbundesamt (KOMPASS) finden Sie unter: http://www.anpassung.net/netzwerk/
Dessau-Roßlau, 17.10.2007
URL dieser Pressemitteilung: http://idw-online.de/pages/de/news230813
Zwiespältige McKinsey-Studie zu Kosten des Klimaschutzes
 Berlin: Für den Bund für Umwelt und Naturschutz Deutschland (BUND) liefert die heute vom Bundesverband der Deutschen Industrie (BDI) veröffentlichte McKinsey-Studie zu den Kosten des Klimaschutzes eine Reihe von Argumenten, warum sich die Industrie ambitionierten Klimaschutzmaßnahmen auf keinen Fall verweigern sollte. Absehbar sei jedoch auch, dass sich Wirtschaftszweige wie die Autoindustrie oder der Energiesektor verstärkten Umweltschutzmaßnahmen mit Hinweis auf die Studie auch künftig verweigern würden. Wenn McKinsey CO2-Minderungen von lediglich 26 bis 31 Prozent als kostengünstig bewerte, liege das daran, dass Schäden durch den Klimawandel und die Kosten notwendiger Schutzmaßnahmen völlig außer acht gelassen worden seien.
Berlin: Für den Bund für Umwelt und Naturschutz Deutschland (BUND) liefert die heute vom Bundesverband der Deutschen Industrie (BDI) veröffentlichte McKinsey-Studie zu den Kosten des Klimaschutzes eine Reihe von Argumenten, warum sich die Industrie ambitionierten Klimaschutzmaßnahmen auf keinen Fall verweigern sollte. Absehbar sei jedoch auch, dass sich Wirtschaftszweige wie die Autoindustrie oder der Energiesektor verstärkten Umweltschutzmaßnahmen mit Hinweis auf die Studie auch künftig verweigern würden. Wenn McKinsey CO2-Minderungen von lediglich 26 bis 31 Prozent als kostengünstig bewerte, liege das daran, dass Schäden durch den Klimawandel und die Kosten notwendiger Schutzmaßnahmen völlig außer acht gelassen worden seien.
Angelika Zahrnt, BUND-Vorsitzende: „Die McKinsey-Studie ist nicht das Produkt einer Umweltorganisation und sie macht aus dem Bundesverband der Deutschen Industrie auch keine ökologische Veranstaltung. Trotzdem kann sie in einigen Bereichen einem effektiven Klimaschutz den Weg bereiten. Vor allem bei den Erneuerbaren Energien und bei der Gebäudesanierung hebt die Studie die Chancen hervor. Die Autohersteller und die Stromkonzerne aber werden sich hinter McKinsey verstecken, wenn von ihnen mehr Verantwortung für den Schutz der Umwelt verlangt wird.“
Der BDI werbe unter Berufung auf den Klimaschutz auch für längere Laufzeiten von Atomkraftwerken. Davon dürfe sich die Bundesregierung jedoch nicht erpressen lassen. Die erst wenige Wochen zurückliegende Pannen-Serie der Atomreaktoren in Krümmel und Brunsbüttel habe gezeigt, dass Atomkraftwerke unverantwortliche Risiken bergen. Hinzu komme, dass die Atomenergie den Ausbau erneuerbarer Energien und damit den Klimaschutz blockiere.
Große Lücken weise die McKinsey-Studie bei den Sparpotenzialen von Autos und den Ausbauchancen der klimafreundlichen Kraft-Wärme-Kopplung (KWK) auf. So werde angenommen, dass technische Maßnahmen an Pkw deren CO2-Ausstoß lediglich um rund acht Millionen Tonnen pro Jahr verringern könnten. Dies blende die möglichen Minderungseffekte durch sparsame Autos vollständig aus. Auch der von McKinsey prognostizierte KWK-Ausbau bleibe hinter der vom BDI selbst abgegebenen Zusage zurück.
Zahrnt: „BDI-Präsident Jürgen Thumann sollte sich noch einmal die Prognos-Studie des Bundeswirtschaftsministeriums ansehen. Sie weist nach, dass auch bei einem Atomausstieg die CO2-Emissionen bis 2020 um 40 Prozent verringert werden können. Ein ambitionierter Klimaschutz ist nicht nur für den Schutz der Erdatmosphäre dringend erforderlich, auch die Wirtschaft würde davon profitieren.“
Pressekontakt:
Gerhard Timm, BUND-Bundesgeschäftsführer, Tel. 030-27586-431 bzw. Rüdiger Rosenthal, BUND-Pressestelle, Tel. 030-27586-425/-489, Fax: -449, Mobil: 0171-8311051, E-Mail: presse@bund.net
Berlin – Veröffentlicht von pressrelations
Link zur Pressemitteilung: http://www.pressrelations.de/new/standard/dereferrer.cfm?r=297476
Bakterien in Biofilmen halten Uran fest
Uran kommt in unserer Umwelt natürlich vor. In dicht besiedelten Regionen wie Sachsen, wo lange Jahre Uranerz abgebaut wurde, ist es besonders wichtig zu wissen, wie sich Uran in der Natur ausbreitet. Neueste Untersuchungen im Forschungszentrum Dresden-Rossendorf (FZD) belegen, dass Bakterien eine wichtige Rolle beim Transport von Uran in der Umwelt übernehmen können. Die Ergebnisse wurden vor kurzem im Fachjournal „Environmental Science & Technology“ veröffentlicht.
Bakterien sind keine Einzelgänger, vielmehr sind 99 Prozent aller Bakterien in Biofilmen organisiert. Typische Biofilme sind Zahnbeläge oder schleimige Überzüge auf in Gewässer befindlichen Steinen. Biofilme sind allgegenwärtig und treten insbesondere an Grenzflächen zwischen fest und flüssig auf. Ein Biofilm besteht zu 50 bis 95 % aus Wasser. Der Rest setzt sich aus Mikroorganismen und organischen Makromolekülen zusammen. In Biofilmen findet man sehr komplexe und zugleich gut aufeinander abgestimmte Lebensgemeinschaften von Mikroorganismen vor. Dabei kann es zur Ausbildung von Nischen mit unterschiedlichen geochemischen Parametern (z. B. pH-Wert, gelöste Sauerstoffkonzentration) innerhalb des Biofilms kommen. Biofilme sind von Wasserkanälen durchzogen, auf denen den Bakterien Nährstoffe zugeführt und deren Ausscheidungen abtransportiert werden. Auf diese Weise gelangen auch toxische Schwermetalle in den Biofilm und können dort zurückgehalten werden. Somit können Biofilme einen natürlichen Filter für Wasserreinigungs-Prozesse bilden.
Uran kann über das Transportmedium Wasser zu den Biofilmen gelangen. Hierbei spielt die Oxidationsstufe des Urans eine große Rolle: das sechswertige Uran ist wasserlöslich und somit mobil (im Zentrum dieser Verbindung steht das Uranyl-Ion UO22+ – das Uranatom ist von zwei Sauerstoffatomen umgeben), das vierwertige Uran dagegen ist kaum wasserlöslich. Wird das mobile Uran(VI) in einen solchen Biofilm geleitet, ist die Wahrscheinlichkeit groß, dass es durch den Weg von der Oberfläche in das Innere des Biofilms chemisch in vierwertiges Uran umgewandelt wird. Bei dieser Reaktion gibt das Uran(VI) zwei Elektronen ab, allerdings war bisher der genaue Reaktionsvorgang unklar. Die ausgefeilten Analysetechniken, die im FZD zur Verfügung stehen, ermöglichten erstmals die genaue Untersuchung des chemischen Verhaltens von Uran in lebender Umgebung. So konnte die komplexe Wechselwirkung zwischen dem Schwermetall und den Bakterien, die in einem Biofilm leben, aufgedeckt werden. Dieses Wissen könnte in Zukunft dabei helfen, Konzepte für intelligente Sanierungsmaßnahmen zu erstellen.
Den Redox-Prozess von Uran in einem Biofilm hat ein Wissenschaftler-Team um Dr. Thuro Arnold im Forschungszentrum Dresden-Rossendorf in Kooperation mit Prof. Isolde Röske und Dr. Axel Wobus von der Technischen Universität Dresden nun erstmalig untersucht. Mit einem konfokalen Laser-Fluoreszenz-Mikroskop gelang es, die Reduktion von Uran(VI) zum Uran(V) zu visualisieren und spektroskopisch zu identifizieren. Die Forscher gaben zunächst einem der Natur nachempfundenen Biofilm eine wohldefinierte Lösung mit Uranyl(VI)-Ionen bei. Um Uran im Mikroskop sichtbar machen zu können, wird ausgenutzt, dass einige Uran-Verbindungen bei gezielter Laseranregung Lumineszenz zeigen, also nachleuchten. Einmalig ist das per Mikroskop entstandene Bild, auf dem sechs- und fünfwertiges Uran gleichzeitig zu sehen sind. Da Uran(V) nur kurze Zeit stabil ist, herrscht dieser Oxidationszustand nicht lange vor. Dr. Arnold: „Wir konnten nachweisen, dass die Umwandlung in wasserunlösliches Uran in zwei Etappen vor sich geht. Während der im Biofilm ablaufenden Reaktion gibt das sechswertige Uran erst ein Elektron ab, woraus das fünfwertige Uran entsteht. Für die weitere Umwandlung zum wasserunlöslichen Uran(IV) gibt es zwei Möglichkeiten. Zum einen kann das Uran(V) im Biofilm unter Abgabe eines zusätzlichen Elektrons weiter zu Uran (IV) reduziert oder aber in einem komplizierteren Prozess zu Uran(IV) und Uran (VI) umgewandelt werden. Da das im Biofilm entstandene vierwertige Uran quasi wasserunlöslich ist, fällt es aus und wird im Biofilm festgehalten.“
Eine besondere Leistung der Rossendorfer Wissenschaftler besteht zudem darin, dass sie gleichzeitig mit dem mikroskopischen Nachweis der Reduktion von Uran in einem Biofilm die genaue Wertigkeit der Uran-Verbindungen mit der Methode der Laser-Fluoreszenz-Spektroskopie nachweisen konnten. Dr. Arnold: „Wir wollen die von uns entdeckten Prozesse nun noch besser verstehen lernen, um dieses Wissen beispielsweise in intelligente Sanierungsprozesse einfließen zu lassen.“ Dafür werden derzeit die Untersuchungsgeräte weiter verfeinert und verbessert. Jetzt schon können Uran-Partikel und deren genaue chemische Form, in Biofilmen identifiziert werden. Bald schon sollen mit der Fluoreszenz-Spektroskopie auch zeitaufgelöste Informationen zu gelösten Uranverbindungen in Biofilmen möglich sein, so dass die Kombination der beiden Methoden dann sogar zur Untersuchung von Wechselwirkungen von Zellen mit fluoreszierenden Schwermetallen geeignet sein wird.
Veröffentlichung:
K. Großmann, T. Arnold, E. Krawczyk-Bärsch, S. Diessner, A. Wobus, G. Bernhard, R. Krawietz, „Identification of fluorescent U(V) and U(VI) Microparticles in a multispecies biofilm by Confocal Laser Scanning Microscopy and Fluorescence Spectroscopy „, in: Environmental Science & Technology, Vol. 41, No. 18: September 15, 2007.
Weitere Informationen:
Dr. Thuro Arnold
Forschungszentrum Dresden-Rossendorf (FZD)
Institut für Radiochemie
Tel.: +49 351 260 – 2432
Email: t.arnold@fzd.de
Prof. Dr. Isolde Röske
Technische Universität Dresden
Lehrstuhl für Angewandte Mikrobiologie
Tel.: +49 351 – 46 33 29 05
Email: roeske_i@rcs.urz.tu-dresden.de
Pressekontakt:
Dr. Christine Bohnet
Forschungszentrum Dresden-Rossendorf (FZD) – Presse- und Öffentlichkeitsarbeit
Bautzner Landstr. 128, 01328 Dresden
Tel.: 0351 260 – 2450 oder 0160 969 288 56
Fax: 0351 260 – 2700
Email: c.bohnet@fzd.de
http://www.fzd.de
Ein Bach voller unentdeckter Bakterien
Wissenschaftler der Deutschen Sammlung von Mikroorganismen und Zellkulturen (DSMZ) in Braunschweig haben in Niedersachsen neue Bakterienarten entdeckt.
Die sieben Neuisolate stammen aus dem Westerhöfer Bach im Harz und gehören den Gattungen Flavobacterium und Pedobacter an.
Dipl.-Biol. Milena Wozniczka , Presse- und Öffentlichkeitsarbeit
DSMZ – Deutsche Sammlung von Mikroorganismen und Zellkulturen GmbH
22.10.2007
Der Westerhöfer Bach im Harz war schon im Frühjahr Fundstätte einer neuen Bakteriengattung: vor einem halben Jahr haben die Braunschweiger Biologen dort Deefgea rivuli entdeckt.
Der Westerhöfer Bach im Harz war schon im Frühjahr Fundstätte einer neuen Bakteriengattung: vor einem halben Jahr haben die Braunschweiger Biologen dort Deefgea rivuli entdeckt.
Bemerkenswert ist der hohe Gehalt des Westerhöfer Bachs an Calcium und Magnesium, die ausfallenden Mineralsalze führen zur Bildung von Kalktuffgestein.
Untersuchungen zeigten, dass das Wasser unmittelbar an der Quelle mit seinen sehr geringen Keimzahlen nahezu steril ist. Im weiteren Verlauf des Fließgewässers finden sich zunehmend Bakterien, die vermutlich aus dem Uferbereich eingeschleppt werden. Prof. Dr. Erko Stackebrandt, wissenschaftlicher Geschäftsführer der DSMZ erklärt: „Dabei sehen wir in unseren Kulturschalen immer nur eine kleine Auswahl der tatsächlich vorhandenen bakteriellen Vielfalt. Bislang ist nur etwa ein Prozent aller Bakterien im Labor kultivierbar.“
Die Gattungen Flavobacterium und Pedobacter
Flavobakterien sind häufig gelblich gefärbt. Ihr natürliches Habitat ist weit gefächert, meist findet man sie in aquatischen Gebieten. So auch die neuen Bakterien: Flavobacterium aquidurense und Flavobacterium hercynium. Der Artname „aquidurense“ bezieht sich auf die Widerstandfähigkeit des Bakteriums gegenüber dem besonders harten Wasser des Bachs, „hercynium“ ist die lateinische Form des Harzgebirges. F. aquidurense wurde direkt von der Quelle isoliert, F. hercynium gegen Ende des 320 Meter langen Bachlaufs.
Vertreter der Gattung Pedobacter sind beweglich, meist unpigmentiert und erscheinen als Laborkultur durchscheinend weißlich. Mikroskopisch sind winzig kleinen Stäbchen von etwa 2 mal 0,8 µm (Millionstel Meter) zu erkennen. Die fünf neu entdeckten Arten tragen die Namen P. westerhofensis (aus Westerhof stammend), P. hartonius (zum Harz gehörig), P. duraquae (aus hartem Wasser), P. metabolipauper (mit dürftigem Stoffwechsel), und P. steynii (zu Ehren des Mikrobiologen P.L. Steyn, der die Gattung erstmals beschrieben hat).
Im Rahmen von „Braunschweig – Stadt der Wissenschaft 2007“ haben die ForschungRegion Braunschweig e.V. und die NORD/LB eine Praktikantenbörse für herausragende Abiturienten organisiert. An der DSMZ hat Anique Herling unter der Leitung von Dr. Sabine Gronow ein mikrobiologisches Praktikum absolviert. Gemeinsam haben sie ebenfalls den Westerhöfer Bach im Harz erkundet und dort Wasser- und Bodenproben entnommen. Ziel des dreiwöchigen Praktikums waren die „Feinde“ der Flavobakterien. „Es gibt Viren, die bestimmte Bakteriengruppen gezielt befallen. Diese so genannten Bakteriophagen haben wir untersucht“, erklärt die Biochemikerin Gronow. „Die Untersuchungen sind noch nicht abgeschlossen, aber wir arbeiten zurzeit an sechs Isolaten. Mit etwas Glück findet sich auch dort etwas Neues.“ Forscher müssen also gar nicht in die Tropen, um neue Arten zu entdecken. In Niedersachsen ist das auch vor der eigenen Haustür möglich.
Weitere Informationen:
http://www.dsmz.de – Informationen zur DSMZ in Braunschweig
URL dieser Pressemitteilung: http://idw-online.de/pages/de/news231513
Neue Initiative zur Meeresforschung in der Europäischen Metropolregion Nordwestdeutschland gestartet
Die Max-Planck-Gesellschaft und das Land Niedersachsen stärken die Meeresforschung in Nordwestdeutschland
Dr. Manfred Schloesser, Presse- und Öffentlichkeitsarbeit
Max-Planck-Institut für marine Mikrobiologie
16.10.2007
Durch eine gemeinsame Initiative des Bremer Max-Planck-Instituts für marine Mikrobiologie (MPI) und der Carl von Ossietzky Universität Oldenburg soll das meereswissenschaftliche Potenzial und die Ausstrahlung der Europäischen Metropolregion Nordwestdeutschland durch die Einrichtung von zwei selbständigen Nachwuchsgruppen weiter gestärkt werden. Unterstützt wird das auf 9 Jahre angelegte Projekt von der niedersächsischen Landesregierung, die wesentlich zur Finanzierung beiträgt. Organisatorisch gehören beide Gruppen dem Bremer Max-Planck-Institut an. Als Arbeitsort der Gruppen wurde aber bewusst das ICBM am Standort Oldenburg gewählt, an dem somit eine Außenstelle des Bremer MPIs entsteht. Oldenburg erhält so eine Forschungsstelle der Max-Planck-Gesellschaft (MPG).
Es war unter anderem die in den beiden Universitätsstädten Oldenburg und Bremen vorhandene wissenschaftliche Infrastruktur, die dazu führte, den Großraum Bremen als europäische Metropolregion am 28.04.2005 durch die Ministerkonferenz für Raumordnung anzuerkennen. Besonders enge Kontakte pflegen traditionell die in dieser Region ansässigen meereswissenschaftlichen Institutionen, wobei sich diese zunächst entlang von Süd-Nord-Achsen zwischen Bremen und Bremerhaven sowie Oldenburg und Wilhelmshaven entwickelten. In den zurückliegenden zehn Jahren sind fruchtbare Verbindungen auch länderübergreifend in Ost-West-Richtung gewachsen. Ein gutes Beispiel dafür ist die Forschergruppe „Watt“ der Deutschen Forschungsgemeinschaft, in der seit 7 Jahren Wissenschaftler des Instituts für die Chemie und Biologie des Meeres (ICBM) der Universität Oldenburg , des Max-Planck-Institut für marine Mikrobiologie (MPI) in Bremen sowie des Senckenberg-Instituts in Wilhelmshaven gemeinsam die Bedeutung von biologischen, chemischen und physikalischen Wechselwirkungen für die Entwicklung und Strukturierung des Lebensraums Wattenmeer erforschen.
Entsprechend dem Wunsch von ICBM Oldenburg und MPI Bremen wird die fachliche Ausrichtung der beiden selbständigen Nachwuchsgruppen komplementär zu den schon etablierten Fachrichtungen sein. Geplant ist, in der Meereschemie – konkret in den Bereichen „Organische Geochemie des Meeres“ und in „Anorganische Geochemie des Meeres“ – zwei jungen Forscherpersönlichkeiten im Rahmen des in der MPG bewährten Instrumentariums der selbständigen Nachwuchsgruppe beste Forschungsmöglichkeit zu eröffnen, so Max-Planck-Direktor Prof. Dr. Rudolf Amann. Die Unabhängigkeit und sehr gute Ausstattung der beiden Gruppen wird es ihren Leitern ermöglichen, bei voller wissenschaftlicher Freiheit Profilentwicklung auf höchstem Niveau zu betreiben.
Der Kandidatenauswahl soll noch im Dezember auf einem internationalen Symposium in Oldenburg erfolgen. Der Sicherstellung des wissenschaftlichen Erfolgs der Gruppen dient die regelmäßige Evaluierung durch den Fachbeirat des Max-Planck-Instituts für marine Mikrobiologie in Bremen. Dieses verwaltet die Gruppen und stellt seine wissenschaftlichen Einrichtungen zur Verfügung. Eine Einbindung in die Lehre ist über die Universität Oldenburg und die internationale Max-Planck-Forschungsschule für marine Mikrobiologie möglich.
Rückfragen bitte an den geschäftsführenden Direktor Prof. Dr. Rudolf Amann
MPI für Marine Mikrobiologie, Celsiusstr. 1, D-28359 Bremen
Telefon: 0421 2028 – 930; Fax: 0421 2028 – 790; E-Mail: ramann@mpi-bremen.de
oder an den Pressesprecher
Dr. Manfred Schlösser, Telefon: 0421- 2028704, E-Mail: mschloes@mpi-bremen.de
Weitere Informationen:
http://www.mpi-bremen.de Homepage des Max-Planck-Instituts für marine Mikrobiologie
URL dieser Pressemitteilung: http://idw-online.de/pages/de/news230520
Die Sonne desinfiziert Trinkwasser
 Bei der Eidgenössische Wasserforschungs-Anstalt Eawag wurde ein bestechend einfaches System entwickelt, wie mit Hilfe einer PET-Flaschen und Sonne Flusswasser zu Trinkwasser werden kann. Der Gag des Verfahrens besteht darin, dass die UV-Strahlen der Sonne vorhandene Mikroorganismen im Wasser abtöten.
Bei der Eidgenössische Wasserforschungs-Anstalt Eawag wurde ein bestechend einfaches System entwickelt, wie mit Hilfe einer PET-Flaschen und Sonne Flusswasser zu Trinkwasser werden kann. Der Gag des Verfahrens besteht darin, dass die UV-Strahlen der Sonne vorhandene Mikroorganismen im Wasser abtöten.
Vor allem die einfache Durchführbarkeit besticht: eine verschlossene PET-Flasche wird 6h lang intensiv bestrahlt. Dieses sogenannte “ SODIS“ -Verfahren hat 2006 den Energy Globe Award erhalten, wurde auch von Weltgesundheits-Organisation WHO als offizielle Wasseraufbereitungstechnologie anerkannt, vom Roten Kreuz in ihr Gesundheits- und Hygieneprogramm übernommen. Desinfektion von Wasser, Mehrfachnutzung der PET- Flaschen und Senkung des Brennholzverbrauchs in der Dritten Welt sind überzeugende Argument für SODIS.
Br 10-07
Forschung für die Menschen
Wasser und Energie sind die Voraussetzung allen Lebens – und damit auch der menschlichen Existenz. Die Forscher der Fraunhofer-Gesellschaft erarbeiten Lösungen für die drängenden Probleme der Zukunft: Sie entwickeln heute Technologien, die das Leben morgen einfacher, gesünder und sicherer machen.
Dr. Janine Drexler, Presse und Öffentlichkeitsarbeit
Fraunhofer-Gesellschaft
11.10.2007
Die große Herausforderung des 21. Jahrhunderts ist die Versorgung einer noch immer wachsenden Weltbevölkerung mit den lebensnotwendigen Ressourcen. Mehr als sechs Milliarden Menschen brauchen saubere Luft zum Atmen, Trinkwasser und Grundnahrungsmittel, Arbeit, Wohnraum, Gesundheitsversorgung und sie wünschen sich darüber hinaus Sicherheit. Die Wissenschaftler und Ingenieure der Fraunhofer-Gesellschaft leisten mit ihren Forschungsprojekten einen wichtigen Beitrag zur Lösung aktueller und künftiger Probleme. Energie, Wasser, Gesundheit und Sicherheit sind strategische Schwerpunkte der Fraunhofer-Gesellschaft.
Forschungsschwerpunkt Energie
Der Ölpreis steigt. Die fossilen Rohstoffe gehen zur Neige. Doch die Menschen brauchen in Zukunft Energie – zum Kochen, Heizen, um sich fortzubewegen. Die Konsequenzen liegen auf der Hand: Energie muss künftig effektiver genutzt, Öl zunehmend durch regenerative Energiequellen ersetzt werden. Die Forscher haben diese Herausforderung erkannt. Im Fraunhofer Themenverbund Energie arbeiten sie beispielsweise institutsübergreifend und interdisziplinär an der Entwicklung einer neuen Generation von Brennstoffzellen, an der technischen Verbesserung von Windkraftanlagen, aber auch an Innovationen für die Solartechnik.
Noch spielt die Photovoltaik – die Stromgewinnung aus Sonnenenergie – nur eine geringe Rolle. Doch das soll sich ändern: Die Experten rechnen mit einer Steigerung von derzeit 0,1 Prozent der Gesamtenergieproduktion auf bis zu 50 Prozent im Jahr 2050. Die Voraussetzung hierfür ist allerdings, dass Solarzellen billiger werden. Die Kosten lassen sich auf zweierlei Weise reduzieren: durch Einsparungen bei den Produktionskosten und durch Erhöhung des Wirkungsgrads. Die Forscher verfolgen beide Ansätze und entwickeln Lösungen, die den Unternehmen helfen, die Kosten zu senken und so auf dem Weltmarkt konkurrenzfähig zu bleiben. Derzeit liegen deutsche Solarzellenhersteller hinter Japan an der Weltspitze. Um den Unternehmen den Zugang zu neuen Technologien zu erleichtern, baut die Fraunhofer-Gesellschaft jetzt an zwei Standorten neue Forschungseinrichtungen auf: In Halle an der Saale entsteht das Fraunhofer Center for Silicon Photovoltaics CSP und in Freiberg, Sachsen, das Fraunhofer-Technologiezentrum Halbleitermaterialien THM, eine gemeinsame Abteilung des Fraunhofer-Instituts für Integrierte Systeme und Bauelementetechnologie IISB und des Fraunhofer-Instituts für Solare Energiesysteme ISE.
Außerdem suchen die Forscher am ISE nach neuen Rohstoffen für die Solarzellenproduktion: Bisher benötigen die Hersteller hochreines Silizium, das teuer und nicht unbegrenzt verfügbar ist. Eine Alternative könnte künftig metallurgisches Silizium werden, das günstig ist aber Unreinheiten enthält. Durch verschiedene Prozessschritte wollen die Ingenieure dieses Material solarzellenfähig machen.
Forschungsschwerpunkt Wasser
Sauberes Trinkwasser ist in den meisten Ländern der Welt Mangelware. Für die Zukunft prognostizieren die Experten sogar Kriege ums Wasser. Die verbesserte Gewinnung, Aufbereitung und Verteilung der knappen Ressource ist daher auch bei Fraunhofer ein strategisch wichtiger Forschungsschwerpunkt. Die Wissenschaftler und Ingenieure bündeln jetzt in der neuen Allianz SysWasser ihr Know-how, das sie bei Projekten im In- und Ausland über Jahrzehnte gesammelt haben. Das Spektrum der Kompetenzen reicht von der Trinkwasserreinigung mit Elektroden, UV-Lampen und Membranfiltern bis hin zu Konzepten zum Wassermanagement in Wüstengebieten oder Megastädten.
Auch in Deutschland, einem Land, in dem kein Wassermangel herrscht, können neue Technologien helfen, den Verbrauch von kostbarem Trinkwasser zu verringern. Derzeit benötigt jeder Deutsche täglich 130 Liter sauberes Wasser, wobei er ein Drittel davon durch die Toilette spült. Pure Verschwendung. „Wasser ist eine unserer wertvollsten Ressourcen, viel zu schade, um sie für den Transport von Fäkalien zu vergeuden“, sagt Prof. Dr. Walter Trösch vom Fraunhofer-Institut für Grenzflächen- und Bioverfahrenstechnik IGB in Stuttgart. Gemeinsam mit Dr. Werner Sternad vom IGB und Dr. Harald Hiessl vom Fraunhofer-Institut für System- und Innovationsforschung ISI in Karlsruhe hat er das Dezentrale Urbane Infrastruktursystem DEUS 21 konzipiert und umgesetzt. Dieses Modell arbeitet mit bisher ungenutzen Ressourcen wie Regenwasser. Dieses lässt sich sammeln und dezentral als Brauchwasser ins Versorgungsnetz einspeisen. Für ihre Leistungen erhalten die Forscher den Joseph-von-Fraunhofer-Preis 2007.
Forschungsschwerpunkt Sicherheit
Terroristische Angriffe, Industrieunfälle und Pandemien sind die Bedrohungen der Gegenwart. Forschung ermöglicht, etwas dagegen zu tun – ein Garant für Sicherheit kann sie nicht sein. „Eine der wesentlichen Aufgaben der zivilen Sicherheitsforschung ist, Risiken für unsere Gesellschaft zu erkennen, zu analysieren und schließlich Vorschläge zur Minderung oder Vermeidung des Risikos zu entwickeln“, erklärt Prof. Dr. Hans-Jörg Bullinger, Präsident der Fraunhofer-Gesellschaft. „Um die Sicherheitsforschung voran zu bringen, kann bereits vorhandenes Wissen aus unterschiedlichen Forschungsbereichen genutzt werden.“
Die Fraunhofer-Gesellschaft hat die Sicherheitsforschung als eines von 12 Innovationsthemen identifiziert und liegt damit voll im Trend: Nationale Sicherheitsforschung ist auch ein wichtiger Teil der Hightech-Strategie der Bundesregierung. Und europaweit sollen im 7. Forschungsrahmenprogramm der EU 1,4 Milliarden Euro investiert werden. Hintergrund dieses Engagements ist dabei nicht nur das Bedürfnis des Menschen nach besserem Schutz, sondern auch ein wirtschaftlicher Trend: Sicherheitstechnik entwickelt sich zu einem immer wichtigeren Geschäftsfeld. Der europäische Sicherheitsmarkt liegt derzeit mit 20 Prozent Weltmarkt-Anteil auf Platz zwei hinter den USA. Die Schwerpunkte sind: Sicherheitsdienstleistungen, elektronische Sicherheitssysteme sowie Sicherheit von Information und Kommunikation. Die Fraunhofer-Forscher helfen der Industrie durch neue technologische Entwicklungen, sich auf dem Weltmarkt zu behaupten. Von dieser Forschung profitierten allerdings nicht nur Unternehmen: Die fertigen Produkte kommen dem Menschen zugute, denn sie machen seine Welt ein kleines Stück sicherer.
Forschungsschwerpunkt Gesundheit
Nichts ist mehr wert als ein Menschenleben. Heute können mit Medikamenten und medizintechnischen Geräten Krankheiten besiegt werden, die früher tödliche Folgen gehabt hätte. Gleichzeitig sind die Anforderungen, die an die Wirksamkeit der Medikamente gestellt werden, gestiegen. Die Forscher vom Fraunhofer-Verbund Live Sciences steuern hier neue Technologien bei, die die Entwicklung beschleunigen und gleichzeitig Kosten sparen: In-Vitro-Testplattformen, Arrays zur Identifizierung der Wirkstoffe sowie Analysemethoden zur Untersuchung der Wirkung und Toxizität.
Eine weitere gravierende Veränderung, die sich derzeit vollzieht, ist der demographische Wandel: Schon bald wird das Gros der Bevölkerung der älteren Generation angehören. Die Menschen werden mehr medizinische Versorgung brauchen, viele werden Pflege benötigen. Neue Technologien tragen dazu bei, diese Anforderungen zu erfüllen. Die Forscher der Fraunhofer-Gesellschaft erarbeiten beispielsweise intelligente Umgebungen, die Pflegebedürftigen helfen ihren Alltag allein zu meistern – im Notfall aber sofort Arzt oder Krankenhaus alarmieren. Eine andere vielversprechende Entwicklung ist der Digitale Patientenbegleiter: Das mobile Endgerät – Mobiltelefon oder PDA – erinnert an Arzttermine, gibt beim Einkaufen Ernährungstipps und spornt zu körperlicher Bewegung an. Zielgruppe sind Erwachsene, die ihre Lebens- und Ernährungsgewohnheiten aus medizinischen Gründen umstellen müssen, aber auch übergewichtige Kinder.
Weitere Informationen:
http://www.fraunhofer.de/fhg/press/pi/2007/10/Presseinformation11102007.jsp
URL dieser Pressemitteilung: http://idw-online.de/pages/de/news229720
Integriertes System für die Wassernutzung
Überfüllte Megastädte ohne ausreichende Wasserver- und Abwasser-entsorgung, häufige Hochwasser oder extreme Trockenheit – Probleme, bei denen ein neues urbanes Infrastrukturkonzept helfen kann. Es hat ein flexibles, Wasser sparendes Vakuumkanalnetz.
130 Liter sauberes Wasser verbraucht ein Deutscher pro Tag – nur drei davon trinkt er. Ein Drittel hingegen wird durch die Toilette gespült. „Wasser ist eine unserer wertvollsten Ressourcen, viel zu schade um sie für den Transport von Fäkalien zu vergeuden“, sagt Prof. Dr. Walter Trösch vom Fraunhofer-Institut für Grenzflächen- und Bioverfahrenstechnik IGB in Stuttgart. Gemeinsam mit Dr.-Ing. Werner Sternad vom IGB und Dr.-Ing. Harald Hiessl vom Fraunhofer-Institut für System- und Innovationsforschung ISI in Karlsruhe hat er das Dezentrale Urbane Infrastruktursystem DEUS 21 konzipiert und umgesetzt. Für ihre Leis-tungen erhalten sie den Joseph-von-Fraunhofer-Preis 2007. Die Jury war von der Verfahrenstechnik zur Wasseraufbereitung und dem umfassenden Ansatz für ein effektives Stoffrecycling beeindruckt.
„DEUS ist ein integriertes Modell, das den Rohstoff Wasser vom Wasserhahn bis zur Kläranlage betrachtet“, so Prof. Trösch. „Neu am Ansatz ist, dass wir Regenwasser getrennt vom Schmutzwasser sammeln und nicht ungenutzt über die Abwasserkanalisation ableiten. Wir bereiten es über eine moderne Membrananlage auf.“ Die Poren der Membran sind kleiner als Bakterien und Viren. So werden die Erreger abgetrennt. Heraus kommt keimfreies Pflegewasser, das den Anforderungen der Trinkwasser-Verordnung entspricht. Dieses sehr weiche Wasser fließt durch ein separates Versorgungsnetz zurück in die Haushalte, die es etwa zum Duschen oder auch in der Wasch- und Geschirrspülmaschine nutzen. Die Bewohner sparen dadurch Trinkwasser und somit Geld. Das Abwasser aus den Haushalten wird über eine Vakuumkanalisation gesammelt. Besonderer Vorteil: Die Anlage saugt auch zerkleinerte Küchenabfälle ab, eine Biotonne entfällt. Das Abwasser gelangt in einen hermetisch dichten biologischen Hochleistungsreaktor. Dort sind Rotationsscheibenfilter – poröse, keramische Mikro-Membranen – im Einsatz. Sie filtern alles aus dem Abwasser, was größer ist als 0,2 Mikrometer – auch Bakterien bleiben hier hängen und zersetzen die organischen Abfälle. Das gewonnene Biogas lässt sich nutzen, um Strom und Wärme zu produzieren. Auch Stickstoff und Phosphor werden aus dem Abwasser gewonnen und zu hochwertigem Dünger verarbeitet. Übrig bleibt dann noch das gereinigte Abwasser. Es entspricht den Qualitätsanforderungen der Europäischen Richtlinie an Badegewässer und kann versickert oder in ein Gewässer eingeleitet werden.
Die Pilotanwender in Knittlingen und Neurott schätzen die ökonomischen und ökologischen Vorteile. Argumente, die auch international zählen: Projekte in Namibia, China und Rumänien sind in Planung.
Weitere Informationen:
http://www.fraunhofer.de/fhg/press/pi/2007/10/Mediendienst10s2007Thema4.jsp
URL dieser Pressemitteilung: http://idw-online.de/pages/de/news229749






